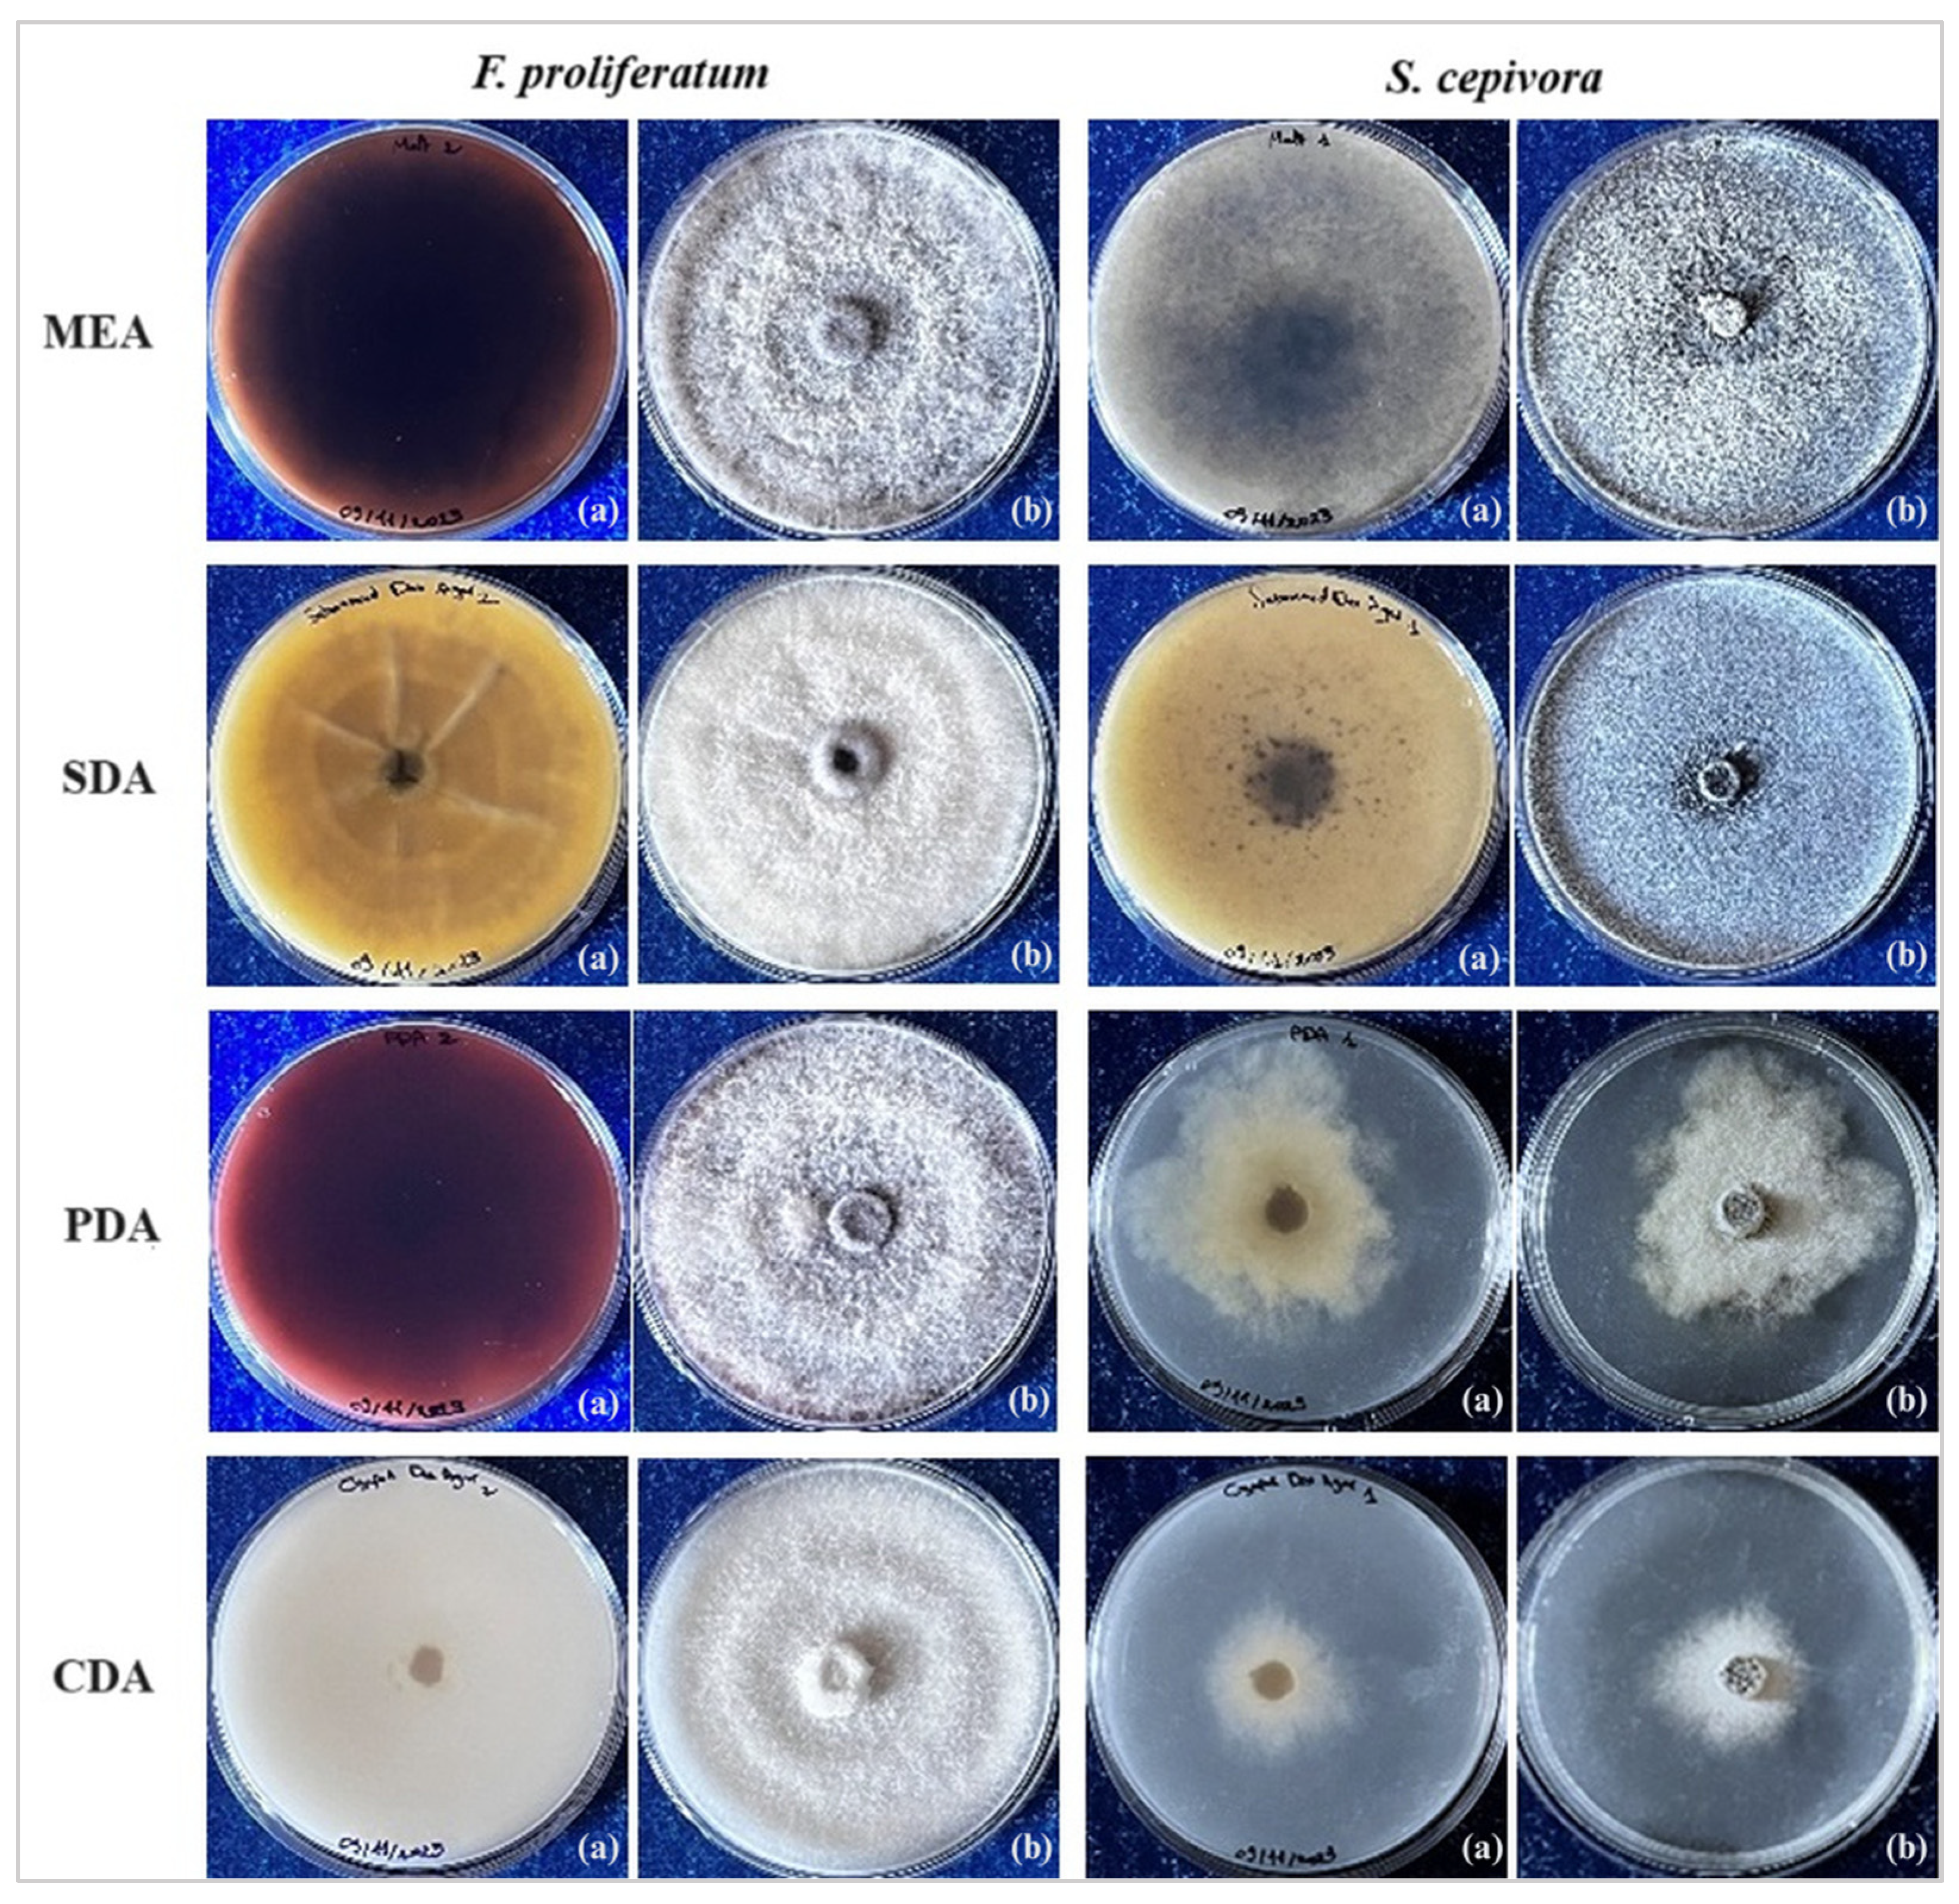
Plants 14 00440 g003

Co-Occurrence of Stromatinia cepivora and Fusarium proliferatum Fungi on Garlic: In Vitro Investigation of Pathogen–Pathogen Interactions and In Planta Screening for Resistance of Garlic Cultivars
Abstract
:1. Introduction
2. Materials and Methods
2.1. Isolation and Identification of the Phytopathogens
2.2. Selective Media Tests
2.3. In Vitro F. proliferatum and S. cepivora Interaction Test
- Growth inhibition of F. proliferatum by S. cepivora:
- Growth inhibition of S. cepivora by F. proliferatum:
2.4. Resistance Against Single Infections of F. proliferatum and S. cepivora
2.4.1. Garlic Cultivars Preparation
2.4.2. In Planta Inoculation of the Pathogens
2.4.3. Inspection and Analysis
- Class 0: cloves were completely asymptomatic, showing no signs of infection (0%).
- Class 1: cloves exhibited small brown spots localized near the basal plate (10%).
- Class 2: moderate infection, with brown spots covering half of the basal plate (35%).
- Class 3: more extensive infection, with brown spots on the whole perimeter of the basal plate, occasionally accompanied by mycelial growth and/or sclerotia (65%).
- Class 4: severe infection, with brown spots on the basal plate extending to the bulb and with prominent visible mycelium and/or sclerotia (90%).
2.5. Resistance Against Simultaneous Infections of F. proliferatum and S. cepivora
2.6. Statistical Analysis
3. Results
3.1. Isolation and Identification of the Phytopathogens
3.2. Selective Media Analysis
3.3. In Vitro F. proliferatum and S. cepivora Interaction Assay
3.4. Resistance Against Single Infections of F. proliferatum and S. cepivora
3.5. Resistance Against Simultaneous Infections of F. proliferatum and S. cepivora
4. Discussion
4.1. Dynamics of the Interaction of S. cepivora and F. proliferatum
4.2. In Vitro Resistance Screening Against S. cepivora and F. proliferatum via Single Inoculation
4.3. In Vitro Resistance Screening Against the Dual Inoculation of F. proliferatum and S. cepivora on Garlic Cultivars
5. Conclusions
Supplementary Materials
Author Contributions
Funding
Data Availability Statement
Acknowledgments
Conflicts of Interest
References
- Amarakoon, S.; Jayasekara, D. A review on garlic (Allium sativum L.) as a functional food. J. Pharmacogn. Phytochem. 2017, 6, 1777–1780. [Google Scholar]
- FAOSTAT. Crop Data. Available online: http://www.fao.org/faostat/en/ (accessed on 12 May 2024).
- Kovarovič, J.; Bystricka, J.; Vollmannová, A.; Tóth, T.; Brindza, J. Biologically valuable substances in garlic (Allium sativum L.)–A review. J. Cent. Eur. Agric. 2019, 20, 292–304. [Google Scholar] [CrossRef]
- Hayat, S.; Ahmad, H.; Ali, M.; Hayat, K.; Khan, M.A.; Cheng, Z. Aqueous garlic extract as a plant biostimulant enhances physiology, improves crop quality and metabolite abundance, and primes the defense responses of receiver plants. Appl. Sci. 2018, 8, 1505. [Google Scholar] [CrossRef]
- Hanci, F. A comprehensive overview of onion production: Worldwide and Turkey. J. Agric. Vet. Sci. 2018, 11, 17–27. [Google Scholar] [CrossRef]
- Bakonyi, J.; Vajna, L.; Szeredi, A.; Tímár, E.; Kovács, G.; Csősz, M.; Varga, A. First report of Sclerotium cepivorum causing white rot of garlic in Hungary. New Dis. Rep. 2011, 23, 2044-0588. [Google Scholar] [CrossRef]
- Crowe, F.; Hall, D.; Greathead, A.; Baghott, K. Inoculum density of Sclerotium cepivorum and the incidence of white rot of onion and garlic. Phytopathology 1980, 70, 64–69. [Google Scholar] [CrossRef]
- Coley-Smith, J. Sclerotium cepivorum Berk. In European Handbook of Plant Diseases; Smith, I.M., Dunez, J., Phillips, D.H., Lelliot, R.A., Archer, S.A., Eds.; Blackwell Scientific Publications: Oxford, UK, 1987; pp. 446–447. [Google Scholar]
- Wu, B.M.; Davis, M.; Turini, T. Developing New Integrated Strategies for Controlling White Rot in Garlic. In Proceedings of the Third Annual Symposium Spotlights Research Spring; California Garlic & Onion Research Advisory Board: Tulare, CA, USA, 2010. Available online: https://beaverturf.com/sites/agscid7/files/coarec/publications/11_white_rot_garlic_0.pdf (accessed on 30 January 2025).
- King, J.; Coley-Smith, J. Production of volatile alkyl sulphides by microbial degradation of synthetic alliin and alliin-like compounds, in relation to germination of sclerotia of Sclerotium cepivorum Berk. Ann. Appl. Biol. 1969, 64, 303–314. [Google Scholar] [CrossRef]
- Fullerton, R.; Stewart, A. Chemical control of onion white rot (Sclerotium cepivorum Berk.) in the Pukekohe district of New Zealand. New Zealand J. Crop Hortic. Sci. 1991, 19, 121–127. [Google Scholar] [CrossRef]
- Sammour, R.H.; Yehia, A.-G.M.; Mustafa, A.; Alhoziem, R. Biology, controlling and genetic variability in Sclerotium cepivorum Berk; the causal agent of Allium white rot disease. Microbiology 2011, 7, 101–111. [Google Scholar]
- Matuo, T.; Miyagawa, M.; Saito, H. Fusarium oxysporum f. sp. garlic nf sp. causing basal rot of garlic. Jpn. J. Phytopathol. 1986, 52, 860–864. [Google Scholar] [CrossRef]
- Rengwalska, M.; Simon, P. Laboratory evaluation of pink root and Fusarium basal rot resistance in garlic. Plant Dis. 1986, 70, 670–672. [Google Scholar] [CrossRef]
- Moharam, M.H.; Farrag, E.S.; Mohamed, M.D. Pathogenic fungi in garlic seed cloves and first report of Fusarium proliferatum causing cloves rot of stored bulbs in upper Egypt. Arch. Phytopathol. Plant Prot. 2013, 46, 2096–2103. [Google Scholar] [CrossRef]
- Llamas, D.P.; Patón, L.G.; Díaz, M.G.; Serna, J.G.; Sáez, S.B. The effects of storage duration, temperature and cultivar on the severity of garlic clove rot caused by Fusarium proliferatum. Postharvest Biol. Technol. 2013, 78, 34–39. [Google Scholar] [CrossRef]
- Tonti, S.; Prà, M.D.; Nipoti, P.; Prodi, A.; Alberti, I. First Report of Fusarium proliferatum Causing Rot of Stored Garlic Bulbs (Allium sativum L.) in Italy. J. Phytopathol. 2012, 160, 761–763. [Google Scholar] [CrossRef]
- Leyronas, C.; Chrétien, P.L.; Troulet, C.; Duffaud, M.; Villeneuve, F.; Morris, C.E.; Hunyadi, H. First report of Fusarium proliferatum causing garlic clove rot in France. Plant Dis. 2018, 102, 2658. [Google Scholar] [CrossRef]
- Medina, Á.; González-Jartín, J.M.; Sainz, M.J. Impact of global warming on mycotoxins. Curr. Opin. Food Sci. 2017, 18, 76–81. [Google Scholar] [CrossRef]
- Palmero, D.; De Cara, M.; Iglesias, C.; Moreno, M.; Gonzalez, N.; Tello, J. First report of Fusarium proliferatum causing rot of garlic bulbs in Spain. Plant Dis. 2010, 94, 277. [Google Scholar] [CrossRef] [PubMed]
- Simay, E. Garlic rot caused by Fusarium proliferatum (Matsushima) Nirenferg var. minus Nirenferg in Hungary. Növényvédelem 1990, 26, 397–399. [Google Scholar]
- Seefelder, W.; Gossmann, M.; Humpf, H.-U. Analysis of fumonisin B1 in Fusarium proliferatum-infected asparagus spears and garlic bulbs from Germany by liquid chromatography−electrospray ionization mass spectrometry. J. Agric. Food Chem. 2002, 50, 2778–2781. [Google Scholar] [CrossRef] [PubMed]
- Stankovic, S.; Levic, J.; Petrovic, T.; Logrieco, A.; Moretti, A. Pathogenicity and mycotoxin production by Fusarium proliferatum isolated from onion and garlic in Serbia. Eur. J. Plant Pathol. 2007, 118, 165–172. [Google Scholar] [CrossRef]
- Wang, H.; Ma, S.; Xia, Q.; Zhao, Z.; Chen, X.; Shen, X.; Yin, C.; Mao, Z. The interaction of the pathogen Fusarium proliferatum with Trichoderma asperellum characterized by transcriptome changes in apple rootstock roots. Physiol. Mol. Plant Pathol. 2022, 121, 101894. [Google Scholar] [CrossRef]
- Moharam, M.H.; Asran, M.R.; Ghanem, S.A. Factors affecting the infection by Fusarium oxysporum and F. proliferatum and the progress of garlic clove rot disease during storage. J. Sohag Agriscience (JSAS) 2023, 8, 77–84. [Google Scholar] [CrossRef]
- Desjardins, A. Fusarium mycotoxins: Chemistry, genetics and biology. J. Agric. Sci. 2006, 145, 539. [Google Scholar] [CrossRef]
- Li, T.; Gong, L.; Wang, Y.; Chen, F.; Gupta, V.K.; Jian, Q.; Duan, X.; Jiang, Y. Proteomics analysis of Fusarium proliferatum under various initial pH during fumonisin production. J. Proteom. 2017, 164, 59–72. [Google Scholar] [CrossRef] [PubMed]
- Rajendran, K.; Ranganathan, K. Biological control of onion basal rot (Fusarium oxysporum f. sp. cepae) by combined application of fungal and bacterial antagonists. J. Biol. Control 1996, 10, 97–102. [Google Scholar]
- Coşkuntuna, A.; Özer, N. Biological control of onion basal rot disease using Trichoderma harzianum and induction of antifungal compounds in onion set following seed treatment. Crop Prot. 2008, 27, 330–336. [Google Scholar] [CrossRef]
- Wille, L.; Messmer, M.M.; Studer, B.; Hohmann, P. Insights to plant–microbe interactions provide opportunities to improve resistance breeding against root diseases in grain legumes. Plant Cell Environ. 2019, 42, 20–40. [Google Scholar] [CrossRef] [PubMed]
- Fang, X.-l.; Zhang, C.-x.; Nan, Z.-b. Research advances in Fusarium root rot of alfalfa (Medicago sativa). Acta Prataculturae Sin. 2019, 28, 169. [Google Scholar] [CrossRef]
- Gordon, T.R. Fusarium oxysporum and the Fusarium wilt syndrome. Annu. Rev. Phytopathol. 2017, 55, 23–39. [Google Scholar] [CrossRef] [PubMed]
- Tollenaere, C.; Susi, H.; Laine, A.-L. Evolutionary and epidemiological implications of multiple infection in plants. Trends Plant Sci. 2016, 21, 80–90. [Google Scholar] [CrossRef] [PubMed]
- Abdullah, A.S.; Moffat, C.S.; Lopez-Ruiz, F.J.; Gibberd, M.R.; Hamblin, J.; Zerihun, A. Host–multi-pathogen warfare: Pathogen interactions in co-infected plants. Front. Plant Sci. 2017, 8, 1806. [Google Scholar] [CrossRef] [PubMed]
- Susi, H.; Barrès, B.; Vale, P.F.; Laine, A.-L. Co-infection alters population dynamics of infectious disease. Nat. Commun. 2015, 6, 5975. [Google Scholar] [CrossRef] [PubMed]
- Brown, W., II. A method of isolating single strains of fungi by cutting out a hyphal tip. Ann. Bot. 1924, 38, 402–404. [Google Scholar]
- Esler, G.; Coley-Smith, J. Resistance to Sclerotium cepivorum in Allium and other genera. Plant Pathol. 1984, 33, 199–204. [Google Scholar] [CrossRef]
- Manandhar, H.K.; Timila, R.D.; Sharma, S.; Joshi, S.; Manandhar, S.; Gurung, S.B.; Sthapit, S.; Palikhey, E.; Pandey, A.; Joshi, B. A Field Guide for Identification and Scoring Methods of Diseases in the Mountain Crops of Nepal; Bioversiy International: Pokhara, Nepal, 2016. [Google Scholar]
- Mondani, L.; Chiusa, G.; Battilani, P. Fungi associated with garlic during the cropping season, with focus on Fusarium proliferatum and F. oxysporum. Plant Health Prog. 2021, 22, 37–46. [Google Scholar] [CrossRef]
- Leslie, J.F.; Summerell, B.A. The Fusarium Laboratory Manual; John Wiley & Sons: Hoboken, NJ, USA, 2008. [Google Scholar]
- Gálvez, L.; Palmero, D. Fusarium dry rot of garlic bulbs caused by Fusarium proliferatum: A review. Horticulturae 2022, 8, 628. [Google Scholar] [CrossRef]
- Yuan, X.; Chen, F. Cocultivation study of Monascus spp. and Aspergillus niger inspired from Black-Skin-Red-Koji by a double-sided petri dish. Front. Microbiol. 2021, 12, 670684. [Google Scholar] [CrossRef] [PubMed]
- Akter, U.H.; Begum, F.; Islam, M.R.; Khatun, M.R.; Islam, M.M. Screening of Selected Garlic Varieties Against White Rot Disease Caused by Sclerotium cepivorum at Dhaka City of Bangladesh. Am. J. Plant Biol. 2021, 6, 53–59. [Google Scholar] [CrossRef]
- Coley-Smith, J.; Entwistle, A. Susceptibility of cultivars of garlic to Sclerotium cepivorum. Plant Pathol. 1988, 37, 261–264. [Google Scholar] [CrossRef]
- Adams, P.; Papavizas, G. Effect of inoculum density of Sclerotium cepivorum and some soil environmental factors on disease severity. Phytopathology 1971, 61, 1253–1256. [Google Scholar] [CrossRef]
- Delgadillo-Sánchez, F.; Heredia-Zepeda, A.; Zavaleta-Mejía, E.; González-Hernández, V.; Torres-Pacheco, I.; Nieto-Ángel, D.; Osada-Kawasoe, S. Susceptibility of different garlic (Allium sativum L.) types to Sclerotium cepivorum Berk. Rev. Chapingo Ser. Hortic. 2001, 7, 171–176. [Google Scholar] [CrossRef]
- Jannatun, N.; Fatema, B.; Md, R.; Habiba, U.; Morshed, M. Screening of selected garlic varieties against Fusarium rot caused by Fusarium proliferatum. SSRG Int. J. Agric. Environ. Sci. 2020, 7, 23–32. [Google Scholar]
- Filyushin, M.A.; Anisimova, O.K.; Kochieva, E.Z.; Shchennikova, A.V. Genome-wide identification and expression of chitinase class I genes in garlic (Allium sativum L.) cultivars resistant and susceptible to Fusarium proliferatum. Plants 2021, 10, 720. [Google Scholar] [CrossRef] [PubMed]
- Fang, X.; Zhang, C.; Wang, Z.; Duan, T.; Yu, B.; Jia, X.; Pang, J.; Ma, L.; Wang, Y.; Nan, Z. Co-infection by soil-borne fungal pathogens alters disease responses among diverse alfalfa varieties. Front. Microbiol. 2021, 12, 664385. [Google Scholar] [CrossRef]
- Lamichhane, J.R.; Venturi, V. Synergisms between microbial pathogens in plant disease complexes: A growing trend. Front. Plant Sci. 2015, 6, 141048. [Google Scholar] [CrossRef] [PubMed]
- Marchetto, K.M.; Power, A.G. Coinfection timing drives host population dynamics through changes in virulence. Am. Nat. 2018, 191, 173–183. [Google Scholar] [CrossRef] [PubMed]

| Experiment | Number of Experiments | Number of Replicates | Samples Per Replicate | Statistical Analysis |
|---|---|---|---|---|
| Dual culture experiment of F. proliferatum and S. cepivora on Petri dishes | 3 | 4 | Each replicate consisted of one dual-culture/single-culture petri dish | One-way ANOVA, descriptive statistics, and effect size (η2) |
| Single and dual inoculations of F. proliferatum and S. cepivora on garlic | 3 | 5 | Each replicate included 5 garlic cloves | One-way ANOVA, descriptive statistics, effect size (η2), and Tukey post-hoc test |
Disclaimer/Publisher’s Note: The statements, opinions and data contained in all publications are solely those of the individual author(s) and contributor(s) and not of MDPI and/or the editor(s). MDPI and/or the editor(s) disclaim responsibility for any injury to people or property resulting from any ideas, methods, instructions or products referred to in the content. |
© 2025 by the authors. Licensee MDPI, Basel, Switzerland. This article is an open access article distributed under the terms and conditions of the Creative Commons Attribution (CC BY) license (https://creativecommons.org/licenses/by/4.0/).
Share and Cite
Ounis, S.; Turóczi, G.; Kiss, J. Co-Occurrence of Stromatinia cepivora and Fusarium proliferatum Fungi on Garlic: In Vitro Investigation of Pathogen–Pathogen Interactions and In Planta Screening for Resistance of Garlic Cultivars. Plants 2025, 14, 440. https://doi.org/10.3390/plants14030440
Ounis S, Turóczi G, Kiss J. Co-Occurrence of Stromatinia cepivora and Fusarium proliferatum Fungi on Garlic: In Vitro Investigation of Pathogen–Pathogen Interactions and In Planta Screening for Resistance of Garlic Cultivars. Plants. 2025; 14(3):440. https://doi.org/10.3390/plants14030440
Chicago/Turabian StyleOunis, Samara, György Turóczi, and József Kiss. 2025. "Co-Occurrence of Stromatinia cepivora and Fusarium proliferatum Fungi on Garlic: In Vitro Investigation of Pathogen–Pathogen Interactions and In Planta Screening for Resistance of Garlic Cultivars" Plants 14, no. 3: 440. https://doi.org/10.3390/plants14030440
APA StyleOunis, S., Turóczi, G., & Kiss, J. (2025). Co-Occurrence of Stromatinia cepivora and Fusarium proliferatum Fungi on Garlic: In Vitro Investigation of Pathogen–Pathogen Interactions and In Planta Screening for Resistance of Garlic Cultivars. Plants, 14(3), 440. https://doi.org/10.3390/plants14030440






